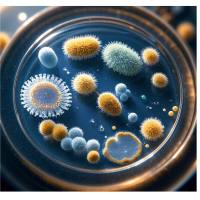
16S/18S/ITS测序

万千商家帮你免费找货
0 人在求购买到急需产品
- 详细信息
- 询价记录
- 技术资料
- 提供商:
上海吉凯基因医学科技股份有限公司
- 服务名称:
单细胞(RNA+ATAC)测序
一、产品简介
单细胞(RNA+ATAC)测序,可实现同一个细胞核基因表达(mRNA)和染色质开放区域(ATAC)的同时检测,表观遗传学和基因表达谱相结合,单细胞水平同时获取2种分子信息可以更深入地表征复杂的细胞群,捕获细胞异质性,发现驱动细胞分化、发育以及疾病发生的基因调控相互作用,是单细胞多组学研究的有力工具
二、技术原理
将样本制备成单细胞核悬液,加入Tn5转座酶对染色质开放区域进行剪切以获得片段化DNA,同时在DNA片段末端添加测序引物,将带有条形码的凝胶珠和单个细胞包裹在油滴中形成GEMs,凝胶珠在油滴内溶解后能够与细胞核裂解释放DNA或者DNA+RNA结合完成单细胞标记。标记完成后,每个样本生成两个互补文库(基因表达文库和ATAC文库),将基因表达和开放染色质图谱准确的链接回同一个细胞。通过一个简单的流程将同一个单细胞的RNA-seq和ATAC-seq的数据相整合,获得转录图谱和染色质景观的一体化视图。
三、文库构建
Tn5转座酶切割后的细胞核与10x Barcode一起形成油包水的凝胶珠,即GEMs,在GEM内,唯一的条形码与单个细胞核内的mRNA和转座DNA片段相连接,孵育后,溶解GEMs,含有Illumina® P5序列、16 nt 10x Barcode(用于ATAC)和Spacer序列的寡核苷酸被释放。在同一区域,含有Illumina® TruSeq Read 1(测序引物1)、16 nt 10x Barcode(用于基因表达GEX)、12 nt unique molecular identifier(UMI)和30 nt poly(dT)序列的引物也被释放。孵化GEMs后,从转置的DNA中产生带有10x的Barcoded DNA(用于ATAC),从多腺苷酸化的mRNA中产生带有10x的Barcoded全长cDNA(用于GEX); 在ATAC文库构建过程中,通过PCR将P7和样品index加到预扩增的DNA中,最终的ATAC文库包含用于Illumina®桥式扩增的P5和P7序列;在基因表达文库的构建中,P5、P7、i7和i5样本indexes以及TruSeq Read 2(引物序列2)通过末端修复、A-tailing、Adaptor Ligation和PCR添加,最终的基因表达库含有Illumina®桥式扩增中使用的P5和P7引物
四、技术优势
一、采用鉴定开放染色质区域的转座酶(Tn5)进行染色质可接近性分析(ATAC-seq)以及基因表达分析(RNA-seq),将表观基因组和基因表达分析结合,加深对细胞类型和状态的鉴定
二、通过对同一细胞进行直接检测来整合基因表达和表观基因组的数据,无需通过计算机推断两者之间的关系,数据准确,同一个样本获得的信息量更大
三、同时鉴定调控元件及其目标基因之间的联系,发现新的基因调控相互作用
四、8个通道微流控系统,每个通道500-10000个细胞核,每次最多可检测80000个细胞核,16通道型号的芯片,一次可以实现16个样本同时上机检测,每个通道最高可以捕获20000个细胞
五、细胞核捕获率高,可达65%
六、样本兼容性好,经过细胞系、原代细胞、冷冻保存样本以及新鲜组织的验证
五、实验流程
六、数据分析
相同基因在表达量和可及性方面的情况
同一份样本RNA+ATAC的U.P.M.A图,以及它们数据整合后的U.P.M.A图
七、应用案列
研究目的:研究小鼠脊髓成年外胚层细胞的系谱潜力
样本信息:小鼠脊髓成体室管膜细胞
测序策略:10x平台,单细胞(RNA+ATAC)测序
捕获细胞数:>4500个细胞
结论:本研究使用单细胞(RNA+ATAC)测序分析了小鼠室管膜细胞中少突细胞marker的染色质可及性,评估了其分化为少突胶质细胞的潜能。结果表明:室管膜细胞具有分化成少突胶质细胞的潜能,Olig2在室管膜细胞中的表达可以特异性、诱导性的产生少突胶质细胞,室管膜来源的少突胶质细胞有助于脊髓损伤后轴突的再髓化和轴突传导功能的改善,揭示了小鼠室管膜细胞在中枢神经系统损伤修复中的作用
研究思路:
研究目的:研究单细胞分辨率下发育中的人类大脑皮层的染色质和基因调控动态变化
样本信息:受孕后第16周(PCW16)、PCW20、PCW21和PCW24的四个时期人胎儿皮质样本,8个样本进行sc RNA-seq,13个样本进行sc ATAC-seq,3个PCW21皮质样本进行sc Multiome-seq(单细胞(RNA+ATAC)-seq)
测序策略:10x平台,scRNA-seq+scATAC-seq以及sc(RNA+ATAC)
捕获细胞数:57868个细胞scRNA-seq;31304个细胞scATAC-seq;8981个细胞sc(RNA+ATAC)-seq
结论:选取不同妊娠时期的胎儿大脑皮层样本,绘制了大脑皮层基因调控元件的活动图谱,生成了独立成的和联合的基因表达和染色质可及性的单细胞图谱,发现了二者在细胞组成上的一致性;然后结合scRNA-seq和scATAC-seq两套数据重建了GluN的发育轨迹,揭示了在GluN分化成熟过程中基因远端顺式调控元件(CRE)调控基因表达(Gene)的机制;最后划分共表达基因模块,继续结合scRNA-seq和scATAC-seq数据解析CRE-Gene对在不同细胞簇、发育阶段和拟时间中的表达情况,并发现及鉴定了两个星形胶质细胞的前体细胞群。
研究思路:
单细胞(RNA+ATAC)测序,可实现同一个细胞核基因表达(mRNA)和染色质开放区域(ATAC)的同时检测,表观遗传学和基因表达谱相结合,单细胞水平同时获取2种分子信息可以更深入地表征复杂的细胞群,捕获细胞异质性,发现驱动细胞分化、发育以及疾病发生的基因调控相互作用,是单细胞多组学研究的有力工具
二、技术原理
将样本制备成单细胞核悬液,加入Tn5转座酶对染色质开放区域进行剪切以获得片段化DNA,同时在DNA片段末端添加测序引物,将带有条形码的凝胶珠和单个细胞包裹在油滴中形成GEMs,凝胶珠在油滴内溶解后能够与细胞核裂解释放DNA或者DNA+RNA结合完成单细胞标记。标记完成后,每个样本生成两个互补文库(基因表达文库和ATAC文库),将基因表达和开放染色质图谱准确的链接回同一个细胞。通过一个简单的流程将同一个单细胞的RNA-seq和ATAC-seq的数据相整合,获得转录图谱和染色质景观的一体化视图。
三、文库构建
Tn5转座酶切割后的细胞核与10x Barcode一起形成油包水的凝胶珠,即GEMs,在GEM内,唯一的条形码与单个细胞核内的mRNA和转座DNA片段相连接,孵育后,溶解GEMs,含有Illumina® P5序列、16 nt 10x Barcode(用于ATAC)和Spacer序列的寡核苷酸被释放。在同一区域,含有Illumina® TruSeq Read 1(测序引物1)、16 nt 10x Barcode(用于基因表达GEX)、12 nt unique molecular identifier(UMI)和30 nt poly(dT)序列的引物也被释放。孵化GEMs后,从转置的DNA中产生带有10x的Barcoded DNA(用于ATAC),从多腺苷酸化的mRNA中产生带有10x的Barcoded全长cDNA(用于GEX); 在ATAC文库构建过程中,通过PCR将P7和样品index加到预扩增的DNA中,最终的ATAC文库包含用于Illumina®桥式扩增的P5和P7序列;在基因表达文库的构建中,P5、P7、i7和i5样本indexes以及TruSeq Read 2(引物序列2)通过末端修复、A-tailing、Adaptor Ligation和PCR添加,最终的基因表达库含有Illumina®桥式扩增中使用的P5和P7引物
四、技术优势
一、采用鉴定开放染色质区域的转座酶(Tn5)进行染色质可接近性分析(ATAC-seq)以及基因表达分析(RNA-seq),将表观基因组和基因表达分析结合,加深对细胞类型和状态的鉴定
二、通过对同一细胞进行直接检测来整合基因表达和表观基因组的数据,无需通过计算机推断两者之间的关系,数据准确,同一个样本获得的信息量更大
三、同时鉴定调控元件及其目标基因之间的联系,发现新的基因调控相互作用
四、8个通道微流控系统,每个通道500-10000个细胞核,每次最多可检测80000个细胞核,16通道型号的芯片,一次可以实现16个样本同时上机检测,每个通道最高可以捕获20000个细胞
五、细胞核捕获率高,可达65%
六、样本兼容性好,经过细胞系、原代细胞、冷冻保存样本以及新鲜组织的验证
五、实验流程
相同基因在表达量和可及性方面的情况
同一份样本RNA+ATAC的U.P.M.A图,以及它们数据整合后的U.P.M.A图
七、应用案列
研究目的:研究小鼠脊髓成年外胚层细胞的系谱潜力
样本信息:小鼠脊髓成体室管膜细胞
测序策略:10x平台,单细胞(RNA+ATAC)测序
捕获细胞数:>4500个细胞
结论:本研究使用单细胞(RNA+ATAC)测序分析了小鼠室管膜细胞中少突细胞marker的染色质可及性,评估了其分化为少突胶质细胞的潜能。结果表明:室管膜细胞具有分化成少突胶质细胞的潜能,Olig2在室管膜细胞中的表达可以特异性、诱导性的产生少突胶质细胞,室管膜来源的少突胶质细胞有助于脊髓损伤后轴突的再髓化和轴突传导功能的改善,揭示了小鼠室管膜细胞在中枢神经系统损伤修复中的作用
研究思路:
研究目的:研究单细胞分辨率下发育中的人类大脑皮层的染色质和基因调控动态变化
样本信息:受孕后第16周(PCW16)、PCW20、PCW21和PCW24的四个时期人胎儿皮质样本,8个样本进行sc RNA-seq,13个样本进行sc ATAC-seq,3个PCW21皮质样本进行sc Multiome-seq(单细胞(RNA+ATAC)-seq)
测序策略:10x平台,scRNA-seq+scATAC-seq以及sc(RNA+ATAC)
捕获细胞数:57868个细胞scRNA-seq;31304个细胞scATAC-seq;8981个细胞sc(RNA+ATAC)-seq
结论:选取不同妊娠时期的胎儿大脑皮层样本,绘制了大脑皮层基因调控元件的活动图谱,生成了独立成的和联合的基因表达和染色质可及性的单细胞图谱,发现了二者在细胞组成上的一致性;然后结合scRNA-seq和scATAC-seq两套数据重建了GluN的发育轨迹,揭示了在GluN分化成熟过程中基因远端顺式调控元件(CRE)调控基因表达(Gene)的机制;最后划分共表达基因模块,继续结合scRNA-seq和scATAC-seq数据解析CRE-Gene对在不同细胞簇、发育阶段和拟时间中的表达情况,并发现及鉴定了两个星形胶质细胞的前体细胞群。
研究思路:
风险提示:丁香通仅作为第三方平台,为商家信息发布提供平台空间。用户咨询产品时请注意保护个人信息及财产安全,合理判断,谨慎选购商品,商家和用户对交易行为负责。对于医疗器械类产品,请先查证核实企业经营资质和医疗器械产品注册证情况。
- 作者
- 内容
- 询问日期
技术资料暂无技术资料 索取技术资料
单细胞(RNA+ATAC)测序
询价